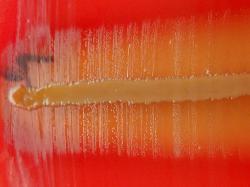

| V-Factor Requirement |
DESCRIPTION
V-factor or nicotinamide adenine dinucleotide (NAD) is a coenzyme involved in redox reactions. Some bacteria cannot produce NAD
and need to get it from the substrate or grow as a satellite of a NAD-producing organism.
V-factor or nicotinamide adenine dinucleotide (NAD) is a coenzyme involved in redox reactions. Some bacteria cannot produce NAD
and need to get it from the substrate or grow as a satellite of a NAD-producing organism.
Satellitism can be demonstrated on an agar medium lacking the V-factor by
cross-inoculating the plate with a feeder strain (e.g. Staphylococcus or
Pseudomonas). The NAD-requiring strain will grow only in the vicinity of the
NAD-producing strain.
V-factor impregnated disks may be used instead of the feeder strain.
NOTES:
NAD is destroyed by autoclaving the medium.
The satellite phenomenon may be difficult to achieve in ordinary agar plates because
blood may contain various amounts of V-factor. For a NAD-free medium autoclaving is
required after adding the blood.
cross-inoculating the plate with a feeder strain (e.g. Staphylococcus or
Pseudomonas). The NAD-requiring strain will grow only in the vicinity of the
NAD-producing strain.
V-factor impregnated disks may be used instead of the feeder strain.
NOTES:
NAD is destroyed by autoclaving the medium.
The satellite phenomenon may be difficult to achieve in ordinary agar plates because
blood may contain various amounts of V-factor. For a NAD-free medium autoclaving is
required after adding the blood.
REFERENCES:
1. H. Raducanescu, V. Bica-Popii,1986. Bacteriologie veterinara, Ed. Ceres, Bucuresti.
2. J. G.Holt et al., 1994.Begey’s manual of Determinative Bacteriology, 9-edition, Williams & Wilkins.
1. H. Raducanescu, V. Bica-Popii,1986. Bacteriologie veterinara, Ed. Ceres, Bucuresti.
2. J. G.Holt et al., 1994.Begey’s manual of Determinative Bacteriology, 9-edition, Williams & Wilkins.
| Antibiogram |
| Encyclopedia |
| Culture media |
| Biochemical tests |
| Stainings |
| Images |
| Movies |
| Articles |
| Identification |
| Software |
(c) Costin Stoica
| R E G N U M PROKARYOTAE |
| Back |
| Actinobacillus pleuropneumoniae (pinpoint colonies) dependent of V factor (NAD) - producing Staphylococcus aureus (yellow line) |